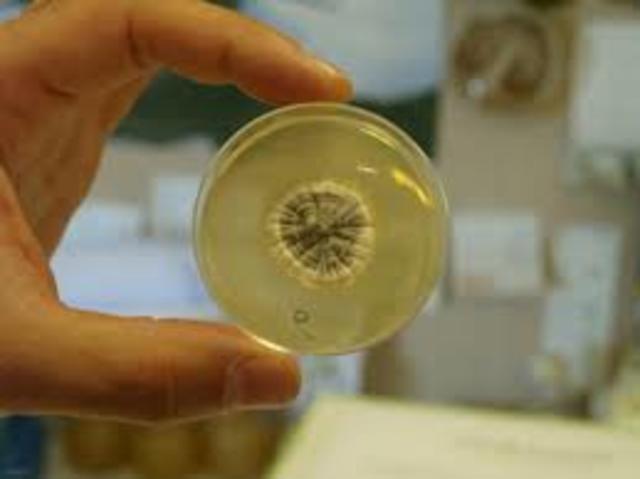
LA PENICILINA

-
AÑO DE CREACIÓN: no se conoce, la primera prueba de su existencia se sitúa en los años 3000 a.C.
QUIEN LA INVENTO: civilización mesopotámica.
¿CUÁNDO APARECIÓ?
No se conoce muy bien cómo ni cuándo apareció. La primera prueba histórica que se tiene de su existencia se sitúa en torno al 3000 a.C. y pertenece a la civilización mesopotámica. Esta es un disco de arcilla con un orificio central y otros más pequeños laterales. -
Año de creación: 105 D.C. La persona que inventó el papel fue Cai Lun . Nacido en la actual provincia China de Guiyang.(enenuco de la corte del emperador chino), lo fabrico con elementos como corteza de arbol, tejidos de seda, moldes.
-
El lugar donde se inventó la brújula es China. ¿Cuándo? se sabe que en el siglo IX pero no se sabe con precisión. Las primeras brújulas eran hechas con una aguja imantada flotando en una vasija con agua, luego para reducir su tamaño y uso se cambió la vasija de agua por un eje rotatorio, añadiendo la “rosa de los vientos”, la cual sirve de guía para calcular direcciones.
-
En el siglo XV (según los descubrimientos se imprimían ya naipes y estampas con motivos religiosos, mediante la aplicación de una plancha de madera grabada y embadurnada con tinta grasa, sobre el papel o el pergamino).
¿Quién es la inventó?, Según las investigaciones, la imprenta fue inventada por lo chinos. -
En el año de 1590: Hans y Zacharias Janssen, un holandés de 10 años, se considera el creador del primer microscopio compuesto, formado por varias lentes en un tubo.
-
El primer inventor del termómetro se estima que fue Galileo Galilei, en 1592. Consistía básicamente en un tubo de vidrio con una esfera de vidrio hueca en su extremo superior, en el que se introducía un líquido que al calentarse subía por el tubo. Al principio, el material utilizado fue el agua, pero llegado a un punto ésta se congelaba (a los O grados Celsius o a los 32 grados Fahrenheit). De manera que el agua fue reemplazada por el alcohol, que no sufre esa reacción.
-
Fue inventada en el año 1879.Su inventor: Thomas Alva Edison.
Los fines que cumple:
Alumbramiento en horas sin luz o en lugares donde no hay luminosidad.
Funcionamiento:
Dispone de un globo de cristal en el que se hace un vacío y dentro del cual se halla un filamento que al ser atravesado por una corriente eléctrica emite luz visible. -
El bacteriólogo británico y Premio Nobel Sir Alexander Fleming descubrió el antibiótico más utilizado en el mundo, la penicilina, en este día en la historia en 1928
Fines que cumple:
Tratar infecciones provocadas por bacterias.
Funcionamiento:
Es un antibiótico del que no se conoce por completo el mecanismo de acción. Su carácter bactericida deriva de su intervención como inhibidor del proceso de síntesis de las bacterias. Debilita la pared bacteriana y ayuda a su eliminación del cuerpo. -
En el año de 1936, Konrad Zuse, ingeniero alemán, diseño y fabricó la Z1, la que para muchos es la primera computadora programable de la historia.
La Z1 era una calculadora mecánica binaria operada con electricidad y que ocupaba una mesa entera, bastante grande por cierto. Los datos los recibía de cintas perforadas, y aunque no permitía un lenguaje de programación tal y como lo entendemos hoy, la Z1 fue la primera máquina programable de la historia. -
Internet se inició en torno al año 1969, cuando el Departamento de Defensa de los EEUU desarrolló ARPANET, una red de ordenadores creada durante la Guerra Fría cuyo objetivo era eliminar la dependencia de un Ordenador Central, y así hacer mucho menos vulnerables las comunicaciones militares norteamericanas. Tanto el protocolo de Internet como el de Control de Transmisión fueron desarrollados a partir de 1973, también por el departamento de Defensa norteamericano
Looking for a timeline maker?
Create timelines for projects, roadmaps, history, lessons, legal cases, and stories with Timetoast. Timetoast is a timeline maker for work, school, research, and stories.